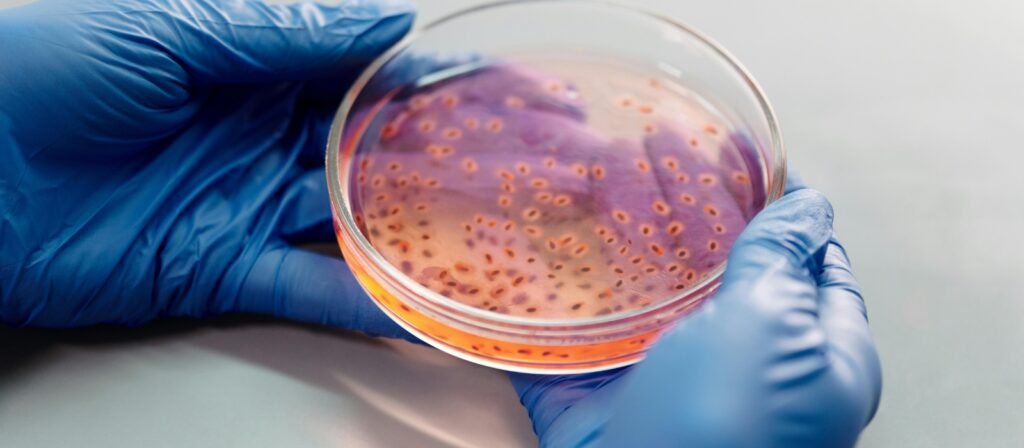

Contagem de Colônias: Avaliação da Carga Microbiana em Alimentos, Cosméticos, Água e Outros Produtos
Em um mundo onde a segurança sanitária é crucial, a contagem de colônias é uma técnica microbiológica indispensável para o controle de qualidade em diversas indústrias. Aplicada rotineiramente em laboratórios de microbiologia, essa metodologia permite quantificar microrganismos viáveis presentes em amostras, sendo amplamente empregada para avaliação da carga microbiana em alimentos, cosméticos, água, fármacos e ambientes.Este post técnico explora, em profundidade, a finalidade da contagem de colônias, suas aplicações práticas, metodologia, interpretação de resultados e os requisitos normativos que regem essa análise essencial.
O que é a Contagem de Colônias?
A contagem de colônias é um método laboratorial utilizado para quantificar as Unidades Formadoras de Colônia (UFC), ou seja, os microrganismos viáveis que crescem e se multiplicam formando colônias visíveis em meio de cultura sólido. Essas colônias resultam, em geral, de uma única célula que se dividiu repetidamente até formar uma massa observável a olho nu.
O procedimento fornece uma estimativa precisa da carga microbiana de uma amostra e serve como indicador fundamental da qualidade microbiológica.

Por que a Contagem de Colônias é Tão Importante?
A contagem de colônias cumpre múltiplas finalidades, como:
-
Avaliar a eficácia de conservantes em cosméticos;
-
Monitorar a potabilidade e qualidade de águas;
-
Comprovar a assepsia de ambientes farmacêuticos;
-
Controlar a eficiência de processos de higienização.
A capacidade de detectar níveis elevados de microrganismos permite que empresas previnam contaminações, garantam conformidade regulatória e evitem prejuízos à saúde pública.
Aplicações da Contagem de Colônias por Setor
1. Indústria de Alimentos
Na cadeia produtiva alimentícia, a contagem de colônias é usada para medir a presença de microrganismos que indicam a qualidade higiênico-sanitária e a segurança do alimento.
Análises comuns:
-
Bactérias aeróbias mesófilas (indicador geral);
-
Coliformes totais e termotolerantes;
-
Salmonella spp., Listeria monocytogenes;
-
Bolores e leveduras.
A contagem elevada de colônias pode indicar falhas na pasteurização, refrigeração, manuseio ou embalagens.
2. Cosméticos e Produtos de Higiene
Cosméticos contaminados representam risco direto à saúde do consumidor. A contagem de colônias é essencial para verificar a eficácia dos conservantes e garantir a ausência de microrganismos patogênicos.
Objetivos principais:
-
Avaliar a carga microbiana total;
-
Garantir a ausência de Pseudomonas aeruginosa e Staphylococcus aureus;
-
Controlar contaminações cruzadas na produção.
3. Controle de Qualidade da Água
A contagem de colônias em amostras de água é vital para atestar a segurança da água potável, mineral, de reuso ou industrial.
Parâmetros microbiológicos analisados:
-
Bactérias heterotróficas;
-
Coliformes totais e Escherichia coli;
-
Pseudomonas spp. (em hemodiálise, por exemplo).
A legislação brasileira, por meio da Portaria GM/MS nº 888/2021, estabelece limites rigorosos para microrganismos presentes na água.
4. Indústria Farmacêutica
Na produção de medicamentos e insumos farmacêuticos, a contagem de colônias ajuda a garantir que não haja crescimento microbiano indesejado, especialmente em ambientes controlados e produtos estéreis.
Exemplos de aplicação:
-
Monitoramento ambiental de áreas limpas (cleanrooms);
-
Verificação da carga microbiana em excipientes e APIs;
-
Testes de esterilidade;
-
Estudos de eficácia de conservantes antimicrobianos.
5. Setores Ambientais
Na microbiologia ambiental, a contagem de colônias permite:
-
Avaliação de bioaerossóis e ar condicionado;
-
Monitoramento de efluentes e águas residuais;
-
Controle microbiológico de solos e fertilizantes orgânicos;
-
Diagnóstico de poluição ambiental por agentes patogênicos.

Como é Realizada a Contagem de Colônias?
O processo envolve diversas etapas padronizadas para garantir a confiabilidade dos resultados.
Etapas principais:
-
Preparação da amostra e diluições seriadas;
-
Semeadura em placas de Petri com meio de cultura adequado;
-
Incubação em estufas bacteriológicas (geralmente entre 24 e 72 horas);
-
Contagem manual ou automática das colônias formadas.
O método mais utilizado é o plaqueamento em superfície (spread plate) ou o plaqueamento em profundidade (pour plate), dependendo da matriz analisada.
Equipamentos Utilizados
Para realizar a contagem de colônias com precisão, são utilizados os seguintes instrumentos:
-
Estufas bacteriológicas (para incubação);
-
Contadores de colônias manuais ou digitais;
-
Cabines de fluxo laminar (para assepsia);
-
Lupas, marcadores, alças de inoculação;
-
Pipetas automáticas e meios de cultura específicos.
O uso de contador de colônias manual é bastante comum em laboratórios de pequeno e médio porte por sua eficiência e custo acessível.
Como Interpretar os Resultados da Contagem de Colônias?
Os resultados são expressos em Unidades Formadoras de Colônia por mililitro (UFC/mL) ou por grama (UFC/g), dependendo da matriz. Para garantir a confiabilidade, recomenda-se contar placas com entre 30 e 300 colônias.
Cálculo típico:
UFC/mL = (Número de colônias) × (1/Fator de diluição) ÷ (Volume semeado)
A interpretação é feita com base nos limites microbiológicos estabelecidos por normas técnicas, como:
-
RDC nº 331/2019 (alimentos);
-
RDC nº 432/2020 (cosméticos);
-
Farmacopeia Brasileira (medicamentos);
-
Portaria nº 888/2021 (água potável).
| Setor | Microrganismos Avaliados | Limite Permitido |
|---|---|---|
| Alimentos | Mesófilos, coliformes, bolores | Varia conforme o tipo de alimento |
| Cosméticos | UFC totais e patógenos específicos | UFC ≤ 10²/g ou mL; ausência de patógenos |
| Água potável | E. coli, coliformes totais | Ausência em 100 mL |
| Medicamentos | Aeróbios, fungos, endotoxinas | UFC ≤ 10²/mL, ausência de patógenos |
| Efluentes | Coliformes fecais | Segundo CONAMA nº 430/2011 |
Fatores que Influenciam a Contagem de Colônias
Para que a análise seja representativa, é fundamental controlar variáveis como:
-
Tipo e qualidade do meio de cultura;
-
Temperatura e tempo de incubação;
-
Diluições seriadas corretas;
-
Manipulação asséptica durante a semeadura;
-
Experiência do operador (em caso de contagem manual).
Qualidade Analítica e Boas Práticas
A contagem de colônias exige o cumprimento rigoroso das Boas Práticas de Laboratório (BPL) e controle de qualidade interno, com:
-
Uso de controles positivos e negativos;
-
Padronização de procedimentos (POP);
-
Treinamento contínuo da equipe;
-
Calibração periódica de equipamentos utilizados na análise.
Limitações da Técnica
Apesar de ser uma técnica padrão ouro, a contagem de colônias tem limitações:
-
Não detecta microrganismos VBNC (viáveis mas não cultiváveis);
-
Demora de 1 a 5 dias para resultados;
-
Pode subestimar contaminações complexas ou polimicrobianas;
-
Requer meios de cultura e incubadoras específicas por tipo de microrganismo.
Avanços Tecnológicos e Tendências
Novas tecnologias estão surgindo para complementar (não substituir) a contagem de colônias:
-
Contadores automatizados com visão computacional;
-
Softwares de captura e análise de imagem;
-
Leituras ópticas integradas com LIMS;
-
Placas cromogênicas e meios rápidos para coliformes e Salmonella.
Ainda assim, a contagem de colônias continua sendo o padrão microbiológico aceito por órgãos reguladores, por oferecer resultados quantitativos reprodutíveis e auditáveis.
Conclusão
A contagem de colônias é uma ferramenta imprescindível para o controle microbiológico em setores que impactam diretamente a saúde pública. Seja para garantir a segurança de alimentos, cosméticos, água ou medicamentos, essa técnica oferece uma avaliação clara e mensurável da carga microbiana presente em produtos e ambientes.
Com base em padrões normativos, equipamentos adequados e uma equipe bem treinada, os laboratórios podem usar a contagem de colônias como um indicador crítico de qualidade, prevenindo riscos sanitários e cumprindo exigências regulatórias nacionais e internacionais.
Deseja saber qual o equipamento ideal para realizar contagem de colônias com precisão no seu laboratório?

A Splabor é uma empresa líder no ramo de fabricação de equipamentos para laboratório, especializada em oferecer uma ampla variedade de equipamentos para laboratórios, materiais e produtos para laboratório de alta qualidade.